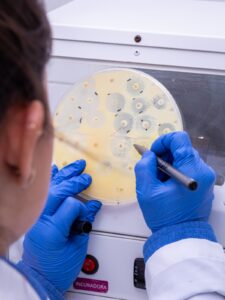
WhatsApp Image 2026 04 07 at 17.30.17 2

Uma startup do Rio Grande do Sul anunciou o lançamento, em âmbito nacional, de uma nova tecnologia voltada ao diagnóstico e à condução terapêutica da mastite em propriedades leiteiras. O SuporTest Antibiograma foi desenvolvido pela Suport D Leite, que atua no desenvolvimento de soluções voltadas à saúde e à produção animal, com foco em diagnóstico, consultoria e tecnologias aplicadas à pecuária leiteira.
O objetivo integrar diferentes etapas do diagnóstico microbiológico diretamente na rotina das fazendas. A iniciativa conta com a parceria do laboratório Labmast, responsável pela produção e distribuição da tecnologia no país.
A ferramenta combina cultura microbiológica do leite, identificação de patógenos e testes de sensibilidade a antibióticos, permitindo que decisões relacionadas ao tratamento sejam tomadas com base em dados obtidos no próprio ambiente de produção. Segundo a empresa, o desenvolvimento da tecnologia é resultado de anos de pesquisa aplicada, com foco na melhoria da eficiência sanitária e produtiva.
A ferramenta combina cultura microbiológica do leite, identificação de patógenos e testes de sensibilidade a antibióticos, permitindo que decisões relacionadas ao tratamento sejam tomadas com base em dados obtidos no próprio ambiente de produção. Segundo a empresa, o desenvolvimento da tecnologia é resultado de anos de pesquisa aplicada, com foco na melhoria da eficiência sanitária e produtiva.
De acordo com informações técnicas divulgadas pela startup, a aplicação do diagnóstico prévio ao tratamento pode contribuir para a redução do uso indiscriminado de antibióticos, além de aumentar a taxa de cura dos casos de mastite. A proposta também busca favorecer maior eficiência econômica nos sistemas de produção leiteira, ao alinhar intervenções terapêuticas com a identificação precisa dos agentes causadores da doença.
Resultados – A tecnologia foi utilizada experimentalmente em uma propriedade localizada no município de Boa Vista do Cadeado (RS), com rebanho de 380 vacas em sistema de ordenha robotizada e compost barn. Os dados apresentados indicam redução na ocorrência de mastite clínica, melhoria em indicadores de saúde do rebanho e maior precisão nas decisões terapêuticas após a adoção da ferramenta. A comparação considera o período anterior à implementação, em 2024, e os resultados obtidos a partir de fevereiro de 2025. O produtor Cristian Tolazzi, responsável pela propriedade, relatou diminuição nos casos clínicos da doença após a utilização do teste antes do período de secagem das vacas.
Com o lançamento nacional, a tecnologia passa a estar disponível para produtores, médicos veterinários e consultores técnicos em diferentes regiões do país. A proposta amplia o acesso a uma tecnologia que alia ciência, praticidade e impacto econômico direto na propriedade.


